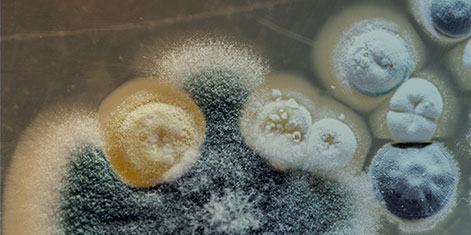
Mold

Minneapolis Emergency Restoration Services – Water, Fire, Storm & Mold Damage
24/7 Emergency Service in the Minneapolis area
When disaster strikes your Minneapolis property, every minute counts. Green Clean provides immediate 24-hour emergency response for residential and commercial properties throughout the Twin Cities metro area. Our IICRC-certified disaster restoration team responds within 60 minutes to minimize damage and begin the recovery process.
Emergency Response Coverage Areas in Minnesota
Green Clean provides rapid disaster response throughout the Minneapolis-St. Paul metropolitan area. Our strategically located teams ensure fast response times to all Twin Cities communities.
Hennepin County
Minneapolis, Bloomington, Eden Prairie, Minnetonka, Plymouth, Edina, St. Louis Park, Richfield
Ramsey County
St. Paul, Roseville, Maplewood, White Bear Lake, Shoreview, New Brighton, Vadnais Heights
Washington County
Woodbury, Cottage Grove, Oakdale, Stillwater, Lake Elmo, Forest Lake
Dakota County
Burnsville, Lakeville, Eagan, Apple Valley, Inver Grove Heights, Rosemount
Before and After Green Clean Water Damage
Emergency Disaster Services We Provide:
Water Damage Emergencies
- Burst pipe repair and water extraction
- Flooding and storm water removal
- Sewage backup cleanup
- Frozen pipe water damage
- Basement flooding response
- Commercial water damage restoration
Fire & Smoke Damage
- Emergency board-up services
- Smoke and soot removal
- Structural fire damage repair
- Odor elimination
- Content restoration
- Insurance documentation
Storm & Natural Disasters
- Tornado damage cleanup
- Wind and hail damage
- Tree damage removal
- Emergency tarping
- Ice dam remediation
- Spring flood response

We have nothing but good things to say about the Green Clean team and their response to our basement sewage backup! They were out within two hours of our call to get us an estimate and started restoration work the next morning. Everyone we worked with was professional and the team when the extra mile to keep us informed and ensure the work was completed to our satisfaction.– Pete StrutzenbergDisaster Response Customer
Why Choose Green Clean
Green Clean is a certified, locally owned cleaning and restoration service for the Twin Cities metro area. With a passion for healthy environments, our tested, safe, and eco-friendly products and processes can help you when disaster strikes with 24-hour emergency help.
 Call 612-789-9600 now for disaster response
Call 612-789-9600 now for disaster response